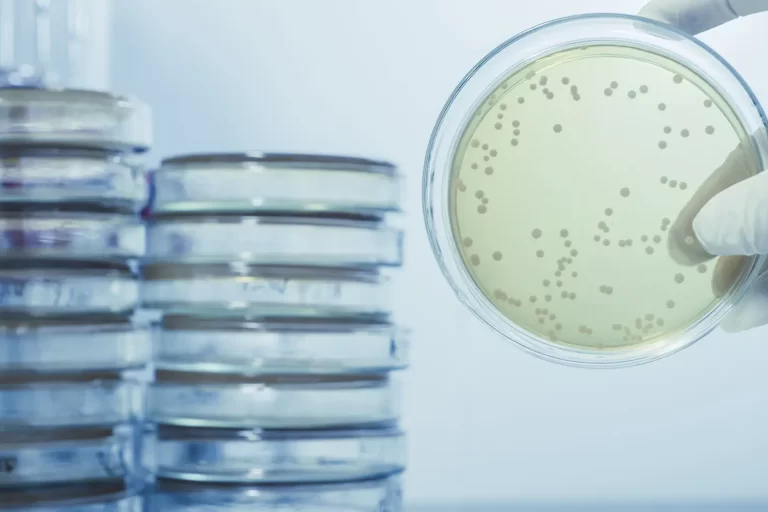
The Role of Chlorine Dioxide in Legionella Control

Welcome to the Scotmas Knowledge Base, where you can find information about our Chlorine Dioxide-based technology and products.
Whether you are a new customer or a long-time partner, this page is an excellent resource for learning more about our water treatment solutions and how they can benefit your business.
As it continues to grow, the Scotmas Knowledge Base will have everything you need to make informed decisions about your water treatment needs. So please take a look around and see what we have to offer.
Please contact our team if you would lile to learn more about how Scotmas can assist you business.